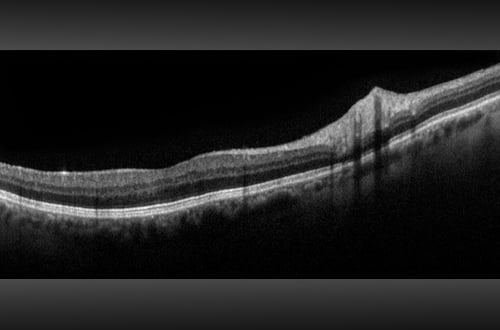

Produkte
Optos führte die UWF™ (Ultra-Weitwinkel Bildgebungstechnologie) ein mit der Augenärzte Augenpathologien entdecken, diagnostizieren, dokumentieren und behandeln können, die sich zuerst in der Peripherie zeigen und mit konventionellen Untersuchungsmethoden und Geräten zunächst unentdeckt bleiben können. Jedes unserer Geräte für hochauflösende Ultra-Weitwinkel-Bildgebung erfasst mittels Laser Scanning Technologie in einer einzigen Aufnahme mehr als 80 % bzw. 200° der Netzhaut. Eine vollständige Liste unserer Geräte mit Ultra-Weitwinkel Bildgebungstechnologie finden Sie unten.
Unten finden Sie eine vollständige Liste unserer Produkte mit Ultra-Weitwinkel Bildgebung.
Um das Gerät zu finden, das am besten auf Ihre Bedürfnisse zugeschnitten ist, wählen Sie bitte die Kategorien aus, die am ehesten der gewünschten Bildmodalität, der Patientendemographie und dem Schwerpunkt Ihrer Praxis entsprechen.
Art des Bildes
Alter
Praxisschwerpunkt
Silverstone
Silverstone ist das derzeit leistungsfähigste Gerät zur Untersuchung der Netzhaut. Als einziges Ultra-Weitwinkel-Bildgebungsgerät mit integriertem, geführtem Swept-Source-OCT liefert Ihnen Silverstone mit einer einzigen Aufnahme und in weniger als ½ Sekunde ein 200° optomap Bild der Netzhaut und ermöglicht zudem geführte OCT-Aufnahmen bis in die Peripherie der Netzhaut.
Entdecken Sie Silverstone

Bildmodi
Warum Silverstone?
optomap kann die Erkennung von Pathologien sowie das Krankheitsmanagement nachweislich verbessern und für effizientere klinische Abläufe sorgen. Mit dem integrierten Swept-Source-OCT ermöglicht Silverstone nun die Untersuchung der Netzhaut vom Glaskörper bis hin zur choroidal-skleralen Grenzfläche.
Bildgebungsmodalitäten und Darstellungsoptionen von Silverstone:
optomap Bildmodi
- Farbe rg
- Sensorisch Rotfrei
- Choroidal
- Autofluoreszenz
- Fluoreszenzangiographie
- Indocyaningrün-Angiographie
- Swept-Source OCT
Darstellungsoptionen
- Standard: 200⁰ Single Einzelaufnahme
- Automontage: bis zu 220°
- Zentraler Pol: Detaillierte Ansicht der Makula
- Stereo: Bildkombination zur Auswertung von Papille und Netzhaut
- OCT: Querschnittaufnahmen okulärer Strukturen einschließlich des Fundus
- OCT: Bis zu 23mm Linienscan und Swept-Source Funktionalität
Bildmodi
Monaco
Monaco ist die einzige UWF-Bildgebung mit integriertem SD-OCT, die Augenärzte dabei unterstützt, ihre klinischen Untersuchungen und die Wirtschaftlichkeit ihrer Praxis zu verbessern. Bildmodalitäten und Darstellungsoptionen sind unten aufgeführt.
Entdecken Sie Monaco

Bildmodi
Warum Monaco?
Monaco ist das einzige Bildgebungssystem mit integriertem SD-OCT, das in weniger als ½ Sekunde mit einer einzigen 200 Grad Aufnahme nahezu die gesamte Netzhaut erfasst und OCT-Querschnittsaufnahmen liefert.
Bildgebungsmodalitäten und Darstellungsoptionen von Monaco:
optomap Bildmodi
- Farbe rg
- Sensorich Rotfrei
- Choroidal
- Autofluoreszenz
- OCT
Darstellungsoptionen
- Standard: 200⁰ Single Einzelaufnahme
- Automontage: bis zu 220°
- Zentraler Pol: Detaillierte Ansicht der Makula
- Stereo: Bildkombination zur Auswertung von Papille und Netzhaut
- OCT: Querschnittaufnahmen okulärer Strukturen einschließlich des Fundus
California
Unser beliebtestes Produkt, California, wurde für die medizinische Bildgebung entwickelt und ist ein Standard für Netzhautscreening-Programme. California ist in verschiedenen Bildgebungsmodalitäten erhältlich. California erzeugt in weniger als ½ Sekunde ein 200°-Bild der Netzhaut mit nur einer einzigen Aufnahme von unübertroffener Klarheit und beeinflusst das Management von Krankheiten wie DR, AMD, Geografische Atrophie, und Uveitis
Entdecken Sie California

Bildmodi
Warum California?
Die drei unterschiedlichen Varianten von California können problemlos auf verschiedene Augenuntersuchungen eingestellt werden. Dank der neuen Hardware und Software können Augenärzte zudem mehr Augenerkrankungen sehen, erkennen und effektiv behandeln und so die Gesundheitsvorsorge der Patienten verbessern.
Bildmodi und Ansichtsoptionen von California:
optomap Bildmodi
- Farbe rg
- Farbe rgb (verfügbar im kombinierten Modell rg/af/fa)
- Sensorisch Rotfrei
- Choroidal
- Autofluoreszenz
- Fluoreszenzangiographie
- Indocyaningrün-Angiographie
Ansichtsoptionen
- Standard: 200⁰ mit einer Aufnahme
- Auto-Montage: Bis zu 220° (nicht erhältlich für fa oder icg)
- Zentraler Pol: Detailliertes Bild der Makula
- Stereo: Bild Gegenüberstellung zur Auswertung des Sehnervenkopfs und der Netzhaut
- 4-in-1 Colour Depth Imaging Tiefendarstellung
Daytona
Daytona erstellt mit nur einer einzigen Aufnahme und in weniger als einer ½ Sekunde ein 200° optomap Bild der Netzhaut von unübertroffener Klarheit. Diese schnelle, einfache und patientenfreundliche Ultraweitwinkel-Bildgebungstechnologie wurde für das Screening gesunder Augen entwickelt und verbessert nachweislich den Praxisablauf und die Patientenbindung.
Entdecken Sie Daytona

Bildmodi
Warum Daytona?
optomap verbessert nachweislich die Erkennung von Pathologien und das Krankheitsmanagement und verbessert die Abläufe in der Klinik. Das Daytona-System ist das am häufigsten verwendete echte UWF-Bildgebungsgerät.
Daytona-Bildmodalitäten und Darstellungsoptionen:
optomap Bildmodi
- Farbe rg
- Sensorisch Rotfrei
- Choroidal
- Autofluoreszenz
Darstellungsoptionen
- Standard 200⁰ Einzelaufnahme
- Automontage: bis zu 220⁰
- Zentraler Pol: detaillierte Ansicht der Makula
- Stereo: Bildkombination zur Auswertung von Papille und Netzhaut